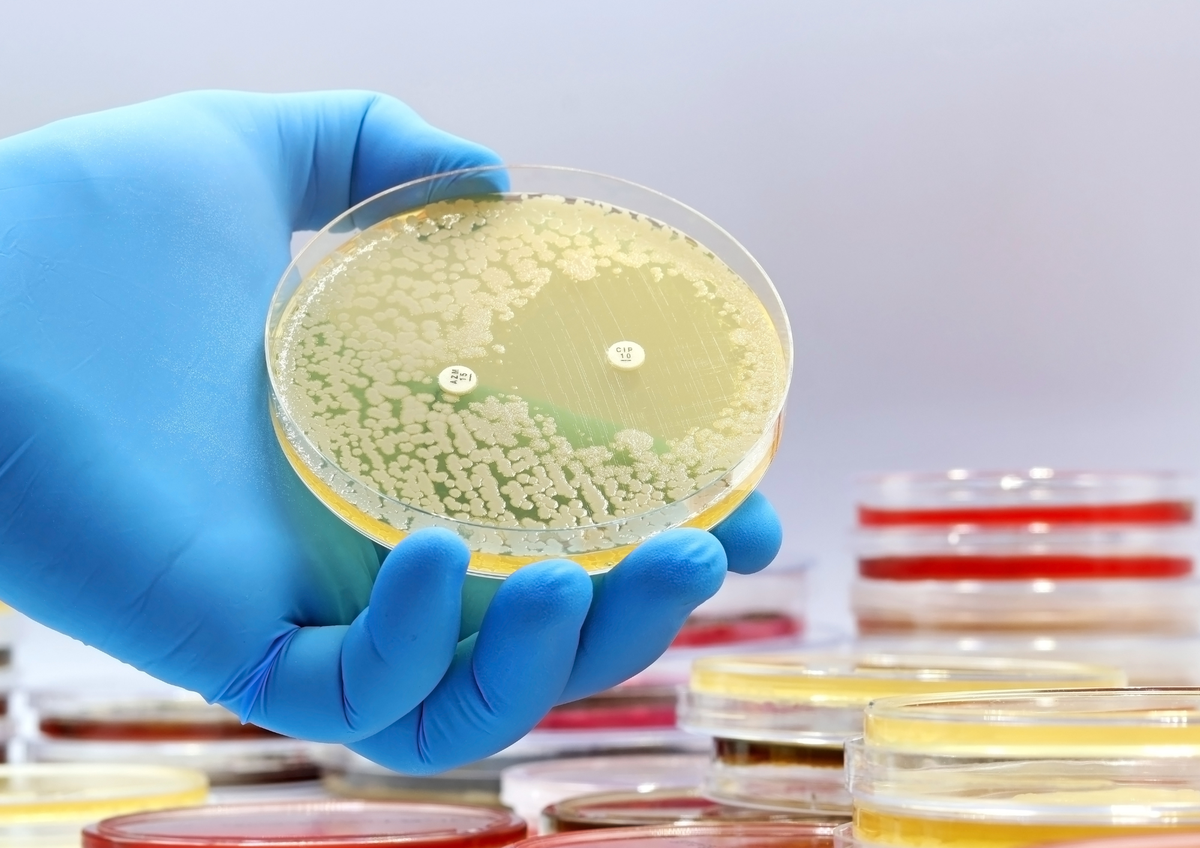

La salud mental es la base de nuestro funcionamiento. Para trabajar en ella necesitamos de rutinas, terapias y una alimentación adecuada que promueva el fortalecimiento de la microbiota intestinal. No basta con hacer ejercicio y visitar al psicólogo, todo lo que somos y sentimos es un reflejo de lo que comemos.
Somos lo que comemos: qué es la microbiota y qué función cumple en la salud mental
La alimentación es más importante de lo que creemos. Para mantener una microbiota sana y funcional es importante pensar en lo que comemos
Expertos en salud y alimentación explican sencillamente qué es la microbiota y cómo podemos mejorar el rendimiento de los organismos naturales del intestino que impactan directamente en el cerebro, protegiendo la salud mental y evitando afecciones como la ansiedad y depresión.
Qué es la microbiota y cómo impacta la alimentación en su funcionamiento
El Centro Médico Quirúrgico de Enfermedades Digestivas (CMED) de España, es una organización de la salud fundada en 2010. Expertos de este organismo explican que la microbiota es el conjunto de bacterias que colonizan la piel, el aparato digestivo y el aparato genital.
Las bacterias de la microbiota intestinal se desarrollan desde el vientre materno y durante toda nuestra vida. La microbiota se relaciona con el organismo de manera simbiótica: las bacterias nos protegen frente a enfermedades, agentes patógenos y metabolizan alimentos. El organismo funciona como casa u hogar de esas bacterias.
La alimentación juega un rol muy importante en el funcionamiento de las bacterias que conforman la microbiota. La flora intestinal se mantiene sana gracias a una dieta variada, equilibrada y rica en vegetales, frutas, carnes y evitando alimentos con alto contenido en grasa y azúcares.
No solo es la cantidad y calidad de la alimentación. También es importante medir los horarios en los que comemos, consumir mucha agua y evitar consumir alimentos con lactosa.
Físicamente podemos ver síntomas de una microbiota dañada o en mal estado principalmente en la piel, las articulaciones, el estado de ánimo y la energía física que puede ser símbolo de anemia.
Microbiota y salud mental ¿Cómo se relacionan?
En nuestra salud mental el estado de la microbiota intestinal tiene un altísimo impacto. La flora del intestino está directamente conectada con el cerebro por medio del intestino delgado.
Gracias a la conexión neuronal establecida por el nervio vago que conecta el intestino con el cerebro, la microbiota ejerce influencia sobre las funciones cerebrales incluido el estado de ánimo y la producción de neurotransmisores como serotonina y dopamina.
Evidencia científica demuestra que la microbiota es clave para comprender los trastornos mentales como la depresión, ansiedad, alzheimer y parkinson. Según la Organización Mundial de la Salud, el suministro de probióticos (bacterias) puede ayudar a mejorar la salud de la microbiota intestinal y contribuir al tratamiento de enfermedades mentales.